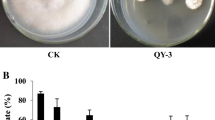

Abstract
Anthracnose is a cosmopolitan fungal disease affecting many tropical and subtropical plants and was first associated with the members of the genus Colletotrichum. In this study, we evaluated the potential antifungal activity of Streptomyces sp. AGS-58 to inhibit anthracnose-causing Colletotrichum spp. on mango fruits. Additionally, a goal of this study was to investigate if the extracellular metabolites produced by the AGS-58 strain could inhibit fungal conidial germination in vitro and control post-harvest anthracnose disease on mango fruits. Antagonistic streptomycetes were initially isolated from Jalapeño chili pepper soil fields and were preliminary selected for their antagonism against C. siamense. The isolate identified as Streptomyces sp. AGS-58 exhibited the highest inhibitory activity against C. siamense CT1. The metabolites obtained from the excreted droplets that accumulated on AGS-58 colonies were studied for their inhibitory effect on conidial germination. According to morphological evidence, extracellular exudates inhibited conidial germ tube formation and hyphal extension. These results suggest that the exudate contains antifungal metabolites that can inhibit the growth of C. siamense. The inhibitory activity was similar to that of Benlate. Spraying mango fruits with the extracellular exudate affected the germination of C. siamense conidia and thus prevented anthracnose progression. To the best of our knowledge, this study suggests the potential of Streptomyces sp. AGS-58 and its extracellular secondary metabolites in controlling anthracnose-causing fungi that infect post-harvest fruits.
Similar content being viewed by others
Avoid common mistakes on your manuscript.
Introduction
Anthracnose is a cosmopolitan fungal disease that affects many tropical and subtropical plants (Cannon et al. 2012). The term anthracnose is used to describe a group of fungal diseases with a particular set of symptoms, including the development of dark, sunken spots, or lesions, often with a raised rim, on affected foliage, stems, and fruits. The symptoms vary according to the plant part affected and can manifest as seedling tumbling, dark circular spots on leaves, stem necrosis, and fruit lesions (Saxena et al. 2016). However, the most commonly observed damage is to the fruits in the form of dark, depressed, and necrotic lesions with concentric acervuline rings, leading to pre- and post-harvest rot (Dean et al. 2012; Saxena et al. 2016).
While Colletotrichum spp. cause a considerable portion of the damage, anthracnose is not limited to one fungal species or genus. The best-known Colletotrichum species is C. gloeosporioides, a species that causes damage to a variety of crops, fruits, vegetables, legumes, and trees. This pathogen is responsible for one of the major pre- and post-harvest diseases affecting many fruits globally (Chowdhury and Rahim 2009; Siddiqui and Ali 2014). In addition, C. gloeosporioides infects unripe fruits and remains latent until the fruits are stored and allowed to ripen. At this stage, the lesions caused by the disease appear in a progressive manner. This critically deteriorates fruit quality, consequently incurring economic losses as the affected fruits do not meet the requirements for consumption and exportation. The losses caused by this disease after harvest range from 5 to 60% of the overall production, whereas in humid conditions, the damage may reach 100% of the export volume (Kamle and Kumar 2016).
Anthracnose affects fruit production from high-value crops in different markets, especially chili pepper, mango, papaya, and banana (Cannon et al. 2012; Ali et al. 2016). Globally, the most important and widespread form of decay in mangoes is anthracnose caused by C. gloeosporioides. However, anthracnose symptoms have also been associated with other Colletotrichum species, e.g., C. asianum, C. fructicola, C. tropicale, C. alienum, and C. siamense (Tovar-Pedraza et al. 2019). C. siamense has been commonly isolated from avocados and mangoes with disease symptoms (Giblin et al. 2018). Nowadays, several Colletotrichum spp. are being isolated from diseased mangoes in southern China, with the dominant species being C. asianum, C. siamense, and C. fructicola, accounting for 30%, 30%, and 25% of isolates, respectively (Li et al. 2019). A further study of diseased mango fruits showed that the Colletotrichum spp. C. asianum, C. fructicola, C. siamense, C. tropicale, and C. scovillei caused lesions, with larger and more evident being caused by C. asianum and C. siamense (Wu et al. 2020).
Currently, the main strategy to extend the shelf life of fresh fruits and to reduce the post-harvest decay of fruits by fungal pathogens is with the use of synthetic fungicides such as benomyl, carbendazim, thiabendazole, and mancozeb. However, there have been increasing concerns regarding the use of these substances owing to both health hazards and the environmental accumulation of toxic residues, which have led to the development of alternative strategies for crop protection (Akem 2006; Edirisinghe et al. 2014). Moreover, a lack of effective control of these pathogens has been observed and is attributable to strains displaying resistance toward these synthetic products (Torres-Calzada et al. 2015), thus highlighting the necessity to search for alternative approaches to manage these diseases (Rojo-Báez et al. 2017). A strategy that fits with the sustainable agriculture concept relies on the post-harvest biological control of fruit disease. This strategy is based on the growing interest in food that is free from chemical pesticide residues. Several groups have been actively studying microbial antagonists to control the post-harvest decay of fresh fruits and vegetables, and it appears to be a promising strategy to manage fruit diseases in a wide range of crops (Di Francesco et al. 2016). Some species of the Streptomyces genus effectively control both pre- and post-harvest anthracnose in several crops by acting against Colletotrichum spp. This significantly impairs the pathogen’s growth (Shimizu et al. 2009; Sadeghian et al. 2016). Streptomycetes are known to secrete a diverse repertoire of secondary metabolites (antibiotics, antifungals, and cell-growth inhibitors) and extracellular enzymes (Chater et al. 2010). The former is associated with the mycelium and/or is secreted into the culture medium. In many Streptomyces spp., liquid droplets accumulate on top of the sporulated colonies. These may be colorless or not and contain vesicles that serve as protein and polyketide antibiotic reservoirs (Schrempf et al. 2011).
In this study, we evaluated the antifungal potential of the Streptomyces sp. AGS-58 against C. siamense that causes post-harvest anthracnose in fruits. Additionally, we examined the inhibition of conidial germination by the extracellular exudates that are accumulated as droplets on the top of colonies, and we explored their ability to control anthracnose in mango fruits.
Materials and methods
Fungal strains and culture conditions
Colletotrichum spp. were isolated from fruits displaying anthracnose symptoms. Colletotrichum strain CT1 was isolated from mango fruits procured form the local market. Monosporic cultures were cultured on potato dextrose agar (PDA; Difco, USA) plates and incubated at 29 °C for 8–10 days. Stock cultures was maintained on PDA slants and stored at 4 °C. Molecular identification and phylogenetic analysis were conducted as described in Online Resource 1 and 2. DNA was amplified with primers for partial actin (ACT), partial chitin synthase (CHS-1), partial glyceraldehyde-3-phosphate dehydrogenase (GAPDH), and rDNA-ITS (ITS) genomic regions.
Isolation of streptomycetes
Soil samples were collected from open cultivation fields of Jalapeño chili pepper in Aguascalientes, Mexico. All samples were collected using an auger by drilling down to a 10 cm depth. They were subsequently placed in presterilized plastic bags and were processed after 36 h. Streptomycete isolation was performed as described previously (Evangelista-Martínez 2014a). Emerging colonies were selected based on the typical morphological features of streptomycete colonies. Pure isolates were obtained by repeated streaking onto fresh International Streptomyces Project media 2 (ISP2) plates. For long-term preservation, a suspension of spores was stored at −20 °C in 20% (w/v) glycerol. A working general inoculum (GI) of spores was prepared to obtain a turbid suspension of 108 CFU/ml.
Antagonistic activity of Streptomyces species against Colletotrichum spp.
The antagonistic assays of streptomycetes against anthracnosis-producing Colletotrichum strain CT1 were conducted by placing 2 μl of the GI onto a Petri dish containing ISP2, at 1 cm distance from the edge. After 30 min of incubation at room temperature, a PDA agar disc of 0.6 cm diameter covered with an actively growing fungal mycelium was punched from sporulating areas near the periphery and was placed at the center of the plates. Cultures were stored at 29 °C ± 2 °C for 7 days. Media plates inoculated with only fungal pathogen were used as controls. The percentage of inhibition (PI) was calculated using the following formula: PI (%) = (FR − AR)/FR × 100 (Evangelista-Martínez 2014a). All measurements were conducted in triplicate.
An initial screening assay to select antagonistic streptomycetes was conducted against C. siamense CT1. Subsequent in vitro assays to evaluate the potential biocontrol activity of the selected Streptomyces strain were performed as dual confrontation tests with the cultures of C. siamense and were contrasted with that of Streptomyces lydicus WYEC 108 (Actinovate®), a biocontrol agent used against fungal root and seed rots (Yuan and Crawford 1995). PI was calculated as previously indicated. All measurements were conducted in triplicate.
Inhibitory effects of extracellular exudates on Colletotrichum spore germination
The inhibitory activity of the extracellular droplet-like exudates from Streptomyces sp. AGS-58 colonies on fungal spore germination was evaluated using a two-step procedure: the production of extracellular droplets and inhibitory assays. Initially, 2 µl of GI was placed at four equidistant points on the edge of NA Petri plates and was allowed to dry completely. After 10 min, 3 μl of the C. siamense CT1 spore suspension (106 spores/ml) was inoculated in the center of the plate. The plates were stored at 29 °C ± 2 °C for 12 days, and extracellular droplets that accumulated on the sporulated colonies were collected each day. For inhibitory tests, the exudates were diluted in sterilized distilled water (SDW) to obtain working solutions (WSs) at the following concentrations: 100, 10, 1, and 0.1 mg/ml. The spore germination inhibition assay was performed using the cavity slide technique using a 30 µl sample containing 15 μl of 2X potato dextrose broth mixed with 5 μl of a freshly harvested fungal spore suspension (106 spores/ml). The slides were immediately seeded with 10 μl of the WS and subsequently mixed and covered with a coverslip. The final concentrations of the exudates added to the mix were 50, 5, 0.5 and 0.05 mg/ml. The prepared slides were maintained in a humid environment in Petri dishes at 29 ± 2 °C under dark conditions. Cavity slides containing only SDW were used as a positive control. After 6–24 h of incubation, spore germination was observed under a contrast phase microscope (Olympus model CX31). The experiment was performed in duplicate, and spore germination was evaluated based on the presence of germ tubes. A conidium was considered germinated if its germ tube was longer than the conidia itself. Results were expressed as the percentage of spores germinated compared to the control using the mean values from duplicate experiments. The percentage of spore germination inhibition was calculated using the following formula: % inhibition of spore germination = (SGC − SGT)/SGC × 100, where SGC is the mean number of germinated spores in the control set, and SGT is the mean number of germinated spores in the test set.
In vivo evaluation of droplet-like exudate from Streptomyces sp. AGS-58 to control anthracnose disease of mango fruits
To evaluate the effect of droplet-like exudates on anthracnose progression, an experiment with detached mango fruits was conducted. A completely randomized experimental design was used along with replicates. Mango fruits (Mangifera indica var. Ataulfo) were obtained from local markets. Quality indices used were uniformity of shape and size, freedom from decay and defects, and flesh color and firmness. Mango fruits were sanitized by soaking in 0.5% sodium hypochlorite solution for 3 min. Subsequently, fruits were rinsed twice in SDW and air-dried inside a laminar flow cabinet. The fruits were then moistened with a stock solution of the concentrated exudate and 50 mg/ml WS; they were then allowed to dry on Whatman paper. Subsequently, a 5 mm diameter C. siamense CT1 mycelial plug was seeded on the fruit surface. After inoculation, the fruits were incubated at 28 °C ± 2 °C in humidity chambers containing wet paper towels. All measurements were conducted in duplicate with three mangoes for chamber.
After 10 days, the diameter of the resulting lesion was measured, and the results were presented as mean. Control fruits were treated with SDW and the commercially available fungicide Benlate® (Benomyl, 50 mg/ml).
Characterization of Streptomyces sp. AGS-58
The morphological, biochemical, and physiological features of the AGS-58 isolate were evaluated as described previously (Shirling and Gottlieb 1966). Bacterial growth and spore production were recorded after a 15-day incubation at 29 °C ± 2 °C. The morphological features were observed on ISP2 medium, while the carbohydrate utilization test was performed in 24-well plates containing International Streptomyces Project agar media 9 supplemented with different carbon sources at 1% (w/v). Growth response was evaluated on diverse culture media. Melanin production was evaluated on tyrosine agar media (ISP 7 medium). A phosphate solubilizing test was conducted using the National Botanical Research Institute's phosphate growth medium (Nautiyal 1999). In addition, bacterial growth of the isolate in a nitrogen-low medium (Ashby) was determined (Franco-Correa et al. 2010). The enzymatic index was determined to identify chitinase, xylanase, lipase, gelatinase, and cellulase activities on the base ISP 9 medium (Evangelista-Martínez 2014b). The tolerance toward sodium chloride and pH was evaluated using ISP 2 media supplemented with 2.5, 5, 7.5, 10, and 15% (w/v) salt and by adjusting the pH to 4–9, respectively. All evaluations were conducted in duplicate. Finally, either the relative susceptibility or the resistance to antimicrobials was studied by the disc diffusion method. Briefly, 0.1 ml of an AGS-58 GI solution was evenly distributed onto Petri plates containing ISP2 media in duplicate. Once the solution was absorbed, an antibiotic multidisc for gram-positive bacteria II (Bio-Rad®, Hercule, CA, USA) was placed on the surface of the media and the plate was incubated at 29 °C ± 2 °C for 15 days.
Molecular identification
The AGS-58 isolate was identified by nucleotide sequence analysis of the ribosomal 16S DNA gene. Genomic DNA was extracted from freshly harvested spores using the Pure Yeast/bact Kit B (Qiagen) (Evangelista-Martínez 2014a). The 16S rDNA gene was amplified using the universal 63F (5‵-CAGGCCTAACACATGCAAGTC-3‵) and 1389R (5‵-ACGGGCGGTGTGTACAAG-3‵) primers (Integrated DNA Technologies Inc) (Osborn et al. 2000). Polymerase chain reaction (PCR) was performed using a 50 µl solution containing 50 ng DNA, 1X PCR HiFi buffer (Invitrogen), 2 mM MgSO4, 0.2 mM of each dNTP (Invitrogen), 0.4 μM of each primer, and 1.25 U Platinum Taq High Fidelity DNA polymerase (Invitrogen). Amplification was conducted in a Veriti thermal cycler (Applied Biosystem®) and consisted of an initial denaturation step at 94 °C for 3 min, followed by 35 cycles at 94 °C for 1 min, 55 °C for 45 s, and 68 °C for 1 min; the final extension was performed at 68 °C for 10 min. The amplified fragment was purified using the PureLink PCR Purification Kit (Invitrogen) and was verified by nucleotide sequencing of both the strands at LANGEBIO (National Laboratory of Genomics for Biodiversity, CINVESTAV Irapuato, Mexico). Using the BLASTN v 2.7.1. software, a 1288-bp fragment of the sequence was analyzed for homology. The 16S rDNA gene sequences from type strains of several genera were retrieved from the nonredundant GenBank database (Altschul et al. 1990). These sequences, along with additional streptomycete strains, were used as a reference and any unidentified or unpublished sequences were not included. A phylogenetic analysis was performed using the Molecular Evolutionary Genetic Analysis software version 7.0 (Kumar et al. 2016). Analysis was conducted using the Jukes-Cantor substitution model, and the tree was constructed using the neighbor-joining method. The partial sequence of the 16S rDNA gene was deposited in the GenBank database under the accession number KY694530.
Screening for antibiotic biosynthetic gene clusters
PCR screening for the biosynthetic genes involved in the production of antimicrobial molecules by Streptomyces sp. AGS-58 was based on amplifications with specific primers. Polyketide synthase (PKS) type I gene fragments were amplified using the following degenerate primers: K1F 5‵-TSAAGTCSAACATCCGBCA-3‵ and M6R 5‵-CGCAGGTTSCSG TACCAGTA-3‵. Non-ribosomal peptide synthetase (NRPS) gene fragments were amplified using the following degenerate primers: A3F 5‵-GCSTACSYSATSTACACSTCSGG-3‵ and A7R 5‵-SASGTCVCCSGTSCGGTAS-3‵ (Ayuso-Sacido and Genilloud 2005). Gene fragments of the PKS type II gene were amplified using the degenerate primers KSα 5‵-TSGRCTACRTCAACGGSCACGG-3‵ and KSβ 5‵-TACSAGTCSWTCGCCTGGTTC-3‵ (González et al. 2005). Each reaction mixture (25 μl final volume) comprised 50 ng of DNA template, 1X Colorless GoTaq Flexi buffer, 2 mM MgCl2, 0.2 mM of each dNTP (Invitrogen), 0.4 μM of each primer, 1.25 U GoTaq Hot Start polymerase (Promega), and 10% dimethyl sulfoxide. The PCR amplification program was as previously reported (Ayuso-Sacido and Genilloud 2005; González et al. 2005). All amplification products were visualized on 1.5% (w/v) agarose gels prepared in 1X Tris–borate-EDTA buffer (Invitrogen) and were stained with ethidium bromide. Bands in the ranges of 1200–1400, 800–900, and 700 bp were classified as products of the PKS-I, PKS-II, and NRPS genes, respectively.
Statistical analysis
Data are expressed as the means ± standard deviation (SD), and comparisons by one-way ANOVA tests were performed at P = 0.05 using R v2.14.0 statistical software (R Development Core Team®). Mean values were assessed using a Tukey multiple range test.
Results
Isolation and preliminary selection of antagonistic streptomycetes
A total of 68 streptomycete-like strains were isolated and preserved at the Actinomycetes Germplasm Bank at CIATEJ. All strains were evaluated for their ability to inhibit the growth of C. siamense CT1. The results demonstrated that 11 isolates antagonized the fungal pathogen and showed that isolate AGS-58 was one of the most efficacious in inhibiting the growth of the pathogen by > 40% (Table 1).
In vitro antagonist activity of Streptomyces sp AGS-58
To validate the antagonistic potential of Streptomyces sp. AGS-58, an in vitro set of independent experiments was conducted to compare this isolate with S. lydicus WYEC108. The first confrontation experiment was conducted to estimate the inhibitory effect on C. siamense CT1. As observed on Fig. 1, the bacterial-fungal confrontation assay revealed a higher inhibitory activity of Streptomyces sp. AGS-58 on the fungal growth than that of S. lydicus strain WYEC108. Clearly, AGS-58 inhibited mycelial growth up to 50%, while WYEC108 only efficiently decreased the growth of C. siamense until 50% (P < 0.05). For the second antagonist assay, Streptomyces sp. strain AGS-58 showed higher percentages of mycelial growth inhibition than S. lydicus WYEC108 (PI: 66.7% [± 2.8 SD] and 40% [± 1.8 SD], respectively. Streptomyces lydicus could not display greater inhibitory effects than AGS-58, in either case.
Inhibitory activity of Streptomyces sp. AGS-58 and Streptomyces lydicus WYEC108. A) Mean percentage of inhibition of C. siamense CT1 by Streptomyces sp. AGS-58 (black columns) and S. lydicus WYEC108 (gray columns). B) Comparison of inhibition of mycelial growth on C. siamense. *Means with different letter(s) are significantly different (P < 0.05)
Inhibition of Colletotrichum spore germination in vitro is mediated by the extracellular exudate
After collecting the translucent exudate droplets accumulated on top of the AGS-58 strain colonies, a homogenous WS was prepared (100 mg/ml). Mixtures of the C. siamense conidial suspension and the WS were added to the cavity of concave microscope slides and were stored in a humid chamber for 24 h. As observed in Fig. 2A, B, WS concentration was sufficient to completely inhibit the conidial germination of C. siamense CT1, suggesting that the exudates contain antifungal metabolites that have an inhibitory effect on the conidial germination process.
Considering that Colletotrichum is the most important pathogen causing anthracnose disease among all mango production areas worldwide, we evaluated the effects of droplet-like exudates on the vitality of C. siamense CT1 spores. We mixed the WSs with a conidial suspension and incubated them for 6 h (Fig. 3). These mixtures were then assayed, as described above. Quantitatively, the number of germinated spores decreased proportionally to the increase in exudate concentration. Conidial germination was inhibited by < 5% in the presence of 0.05 mg/ml of WSs, whereas the inhibitory activity increased by up to 30% when the WS concentration was higher (> 0.5 mg/ml). Concentrations above 5 mg/ml completely inhibited the spore germination process. Significant differences were observed when the treatments were compared (P < 0.05). Treatment of spores with 50 mg/ml of WS had a lethal effect on conidial germination. Exposure to MS resulted in morphological changes in conidial development, such as reduced conidial germ tubes, limited hyphal extension, and disrupted appressoria formation.
Assay of fruit protection against anthracnose using the extracellular exudate from AGS-58
Applying the exudate onto the mango fruit surface was effective at controlling anthracnose. Mangoes treated with a superficial cover containing the exudate solution before being inoculated with C. siamense CT1 had lesions of reduced size, similar to that observed after treatment with the commercial fungicide (P < 0.05). In contrast, fruits inoculated with the pathogen without previous treatment with a protective agent developed anthracnose lesions. Thus, treatment with the exudate produced by Streptomyces sp. AGS-58 controls C. siamense growth and disease development (Fig. 4).
Morphological, biochemical, and physiological characterization of the AGS-58 isolate
Morphologically, AGS-58 colonies displayed yellow-colored substrate mycelia, white to cream aerial mycelia, and a massive spore mass with a gray-to-black appearance. The sporulation morphology of the aerial hyphae was of rectiflexibiles (Li et al. 2016). In addition, some biochemical and physiological features were observed (Online Resource 3).
Molecular identification and detection of biosynthetic genes
The analysis of the partial 16S rRNA gene sequence (1298 bp) from the AGS-58 isolate revealed a high similarity (98%) with the streptomycete species sequences previously deposited in the GenBank database. This close relation to other Streptomyces species, along with its phenotypic features, confirmed that the AGS-58 isolate belongs to the Streptomyces genus. The phylogenetic tree based on the neighbor-joining method showed that the AGS-58 strain was related to a particular Streptomyces sp. that can produce antimicrobial metabolites, such as S. avermitilis that produces avermectine, a pesticide with activity against insects, mites and ticks, and helminths (Ikeda et al. 2003). Other closely related members included species that can produce antibacterial, antifungal, and herbicide metabolites (Schwartz et al. 2004; Singh et al. 2009; Zhang et al. 2013; Wu et al. 2017). Additionally, the 16S rRNA gene sequences from S. coelicolor 14,426, as well as those from two streptomycete species used as commercial biofungicides (S. lydicus WYEC 108 and S. violaceusniger) were included in the analysis. Both bioagents were clustered within a separate group (Fig. 5). Screening for the antibiotic gene clusters in Streptomyces sp. AGS-58 revealed the presence of PKS type I, PKS type II, and NRPS genes. Specific amplification of chromosomal DNA revealed amplicons of approximately 1,200 bp, 900 bp, and 700 bp for PKS type I, PKS type II, and NRPS genes, respectively (Online Resource 3). For Streptomyces species, the most frequently amplified biosynthetic antibiotic cluster corresponds to PKS-II sequences (71.2%), whereas PKS-I and NRPS are only detected in 48% and 37% of species (González et al. 2005).
Phylogenetic relationship between Streptomyces sp. AGS-58 and closely related members of the genus based on the 16S rDNA gene. The numbers at the nodes represent percentage values that indicate bootstrap support levels (n = 1,000 resamplings). The scale bar represents 0.06 nucleotide substitutions per site
Discussion
Reportedly, suboptimal handling and storage conditions of post-harvest fruits and vegetables led to global losses of around 40%–50% for root crops, fruits, and vegetables (Sawicka 2019). The post-harvest decay of fruits is caused by several fungal and bacterial microorganisms. Primarily, the control of fungal diseases involves the use of synthetic chemical fungicides. However, there is a growing interest in the post-harvest control of fruit decay using alternative biological methods instead of hazardous fungicides, which pose a concern regarding food safety and environmental issues.
Actinobacteria are an important group of plant-associated, spore-forming bacteria that have been studied for their natural ability to use mechanisms for biocontrol, to promote plant growth, and to interact with plants (Palaniyandi et al. 2013). Nowadays, commercially available products based on Streptomyces species have been used to control soil-borne and foliar fungal phytopathogens. For example, Mycostop® contains the S. griseoviridis K61 strain and Actinovate® contains S. lydicus WYEC108. Although several antagonistic streptomycete strains have been studied as potential biocontrol agents, Streptomyces sp. CACIS-1.16CA significantly impairs the mycelial growth of several fungal pathogens, including Colletotrichum sp., a strain that causes anthracnose on Jatropha curcas trees (Evangelista-Martínez 2014a). Furthermore, a preliminary study focused on the novel CACIA-1.46HGO Streptomyces sp. strain demonstrated that the strain produces secondary metabolites and extracellular enzymes that possibly act in a combined manner to inhibit the mycelial growth of some fungal pathogens (Evangelista-Martínez 2014b). Similarly, the abundant production of an extracellular droplet-like exudate by Streptomyces sp. AGS-58 was observed. This exudate may either accumulate on colonies or be released into the media inhibit the mycelial growth of C. siamense (Bonev et al. 2008). An inhibitory effect was also observed against fungi from different genera, including Fusarium, Aspergillus, Corynespora, Lasiodiplodia, Phomopsis, Bipolaris, and Rhizoctonia (Online Resource 4). Moreover, the antagonistic activity displayed by Streptomyces sp. AGS-58 was similar to that of S. lydicus WYEC 108. These antagonistic assays confirm the excellent inhibitory activity of the Streptomyces sp. AGS-58.
The droplets accumulated on Streptomyces sp. AGS-58 colonies were confirmed to have an inhibitory effect on Colletotrichum spore germination. Spore germination in the absence of the inhibitory compound begins with the formation of a germ tube that ultimately elongates and then differentiates into a melanized appressoria (Nesher et al. 2008). In contrast, the exudate from AGS-58 impaired conidial germination by affecting germ tube formation. Many Streptomyces spp. produce these exuded droplets, and the accumulated polyketide-like compounds and proteins participate in defense and survival. The blue droplets that appear on S. coelicolor sporulated lawns contain the colored polyketide actinorhodin and several different proteins arranged into densely packed vesicles (Schrempf et al. 2011). The droplets produced by S. lividans contain vesicles that store enzymes and other specific proteins, as well as the antibiotic undecylprodigiosin. These lipid vesicles inflict lesions on Aspergillus proliferans and Verticillium dahlia conidia and induce damage to Escherichia coli (Schrempf and Merling 2015). The biosynthesis of linearmycin (an antifungal and antibacterial agent) has been linked with the production of extracellular vesicles by Streptomyces sp. Mg1 (Hoefler et al. 2017).
The antibiotics produced by streptomycetes have been used as alternative fungicides in soils to replace synthetic chemical compounds. Reportedly, Streptomyces violaceusniger YCED9 produces nigericin, a guanidylfungin A-like compound, and geldanamycin that inhibit Pythium, Fusarium, and Phytophthora spp. (Trejo-Estrada et al. 1998). Soil samples previously treated with a culture filtrate enriched with azalomycin produced by S. malaysiensis (strain MJM1968) had decreased fungi, including Fusarium oxysporum, Rhizoctonia solani, Cladosporium cladosporioides, Fusarium chlamydosporum, C. gloeosporioides, Alternaria mali, and Pestalotia spp. (Cheng et al. 2010). The extracellular metabolites from Streptomyces violascens MT7 achieved biological control of the toxigenic fungi that cause citrus and papaya rotting, whereas the incidence of the diseases caused by Geotrichum candidatum and Rhizopus stolonifer on oranges and papaya fruits decreased (Choudhary et al. 2015). In addition, a recent study conducted by Boukaew et al. (2021) found that the volatile organic compounds produced by Streptomyces salmonis PSRDC-09 exhibited high antifungal activity against several Colletotrichum spp., thus demonstrating the potential of this genus for controlling fungal diseases.
The typical symptoms of anthracnose in mango fruits are sunken, necrotic, dark brown-to-black lesions that are visible before or after the harvest. The fruits may prematurely drop from their trees. Fruit spots usually coalesce and can eventually penetrate deep into the fruit, resulting in extensive fruit decay (Nelson 2008). The current strategies for anthracnose control being used by farmers include hot water, fungicides, calcium carbonate, natural antioxidants, chitosan, plant extracts and essential oils, and antagonistic microorganisms, which have demonstrated promising results (Korsten 2006; Osorio et al. 2012; Luo et al. 2015; Khaliq et al. 2016; Gonçalves et al. 2021; Khaliq et al 2021; Limon et al. 2021; Aguirre‐Güitrón et al. 2022).
This is the first study that uses extracellular exudate droplets containing vesicles for post-harvest biocontrol purposes. An aqueous solution sprayed onto mango fruits that contained Streptomyces sp. AGS-58 droplets decreased anthracnose to a similar extent as the commercial fungicide benomyl. A significant reduction was observed in the lesion size. Mango crops, in addition to Colletotrichum spp., are particularly susceptible to infection by Lasiodiplodia theobromae, the causal agent of stem-end rot of fruits. Extracellular exudates from Streptomyces sp AGS-58 exerted a protective effect on mango Ataulfo fruits, controlling the damage caused by L. theobromae (Online Resource 5).
These results are promising, as the current control practices rely on synthetic fungicides or on expensive physical treatments (Kumar et al. 2007). Future studies on anthracnose control in detached mango fruits may include correlations with variables that indicate fruit quality, as well as with post-harvest physiologies, such as skin color, firmness, total soluble solids, titratable acidity, ascorbic acid, and cell membrane permeability (Luo et al. 2015; Lawson et al. 2019).
Currently, there is a global trend to develop ecofriendly agrochemicals using microbial metabolites. These metabolites have relatively shorter environmental life spans, are biodegradable, and therefore, represent a lower risk of residual toxicity than conventional halogenated chemical structures (Saxena 2014). In this regard, for the post-harvest control of fungal diseases, more reliable effects may be obtained using technologies that are based on a formulation containing Streptomyces metabolites intended to be sprayed onto fruits. Some benefits may be obtained from the stability of the metabolite formulation rather than using living microorganisms. The use of metabolites instead of strains may trigger streamlining of the processes to replace chemically synthesized pesticides (Rey and Dumas 2017).
References
Aguirre-Güitrón L, Calderón-Santoyo M, Lagarón JM, Prieto C, Ragazzo-Sánchez JA (2022) Formulation of the biological control yeast Meyerozyma caribbica by electrospraying process: effect on postharvest control of anthracnose in mango (Mangifera indica L.) and papaya (Carica papaya L.). J Sci Food Agric 102:696–706. https://doi.org/10.1002/jsfa.11400
Akem CN (2006) Mango anthracnose disease: present status and future research priorities. Plant Pathol J 5:266–273. https://scialert.net/abstract/?doi=ppj.2006.266.273. Accessed 14 May 2021
Ali A, Bordoh PK, Singh A, Siddiqui Y, Droby S (2016) Post-harvest development of anthracnose in pepper (Capsicum spp): Etiology and management strategies. Crop Prot 90:132–141. https://doi.org/10.1016/j.cropro.2016.07.026
Altschul SF, Gish W, Miller W, Myers EW (1990) Basic local alignment search tool. J Mol Biol 215:403–410. https://doi.org/10.1016/S0022-2836(05)80360-2
Ayuso-Sacido A, Genilloud O (2005) New PCR Primers for the screening of NRPS and PKS-I systems in Actinomycetes: detection and distribution of these biosynthetic gene sequences in major taxonomic groups. Microb Ecol 49:10–24. https://doi.org/10.1007/s00248-004-0249-6
Bonev B, Hooper J, Parisot J (2008) Principles of assessing bacterial susceptibility to antibiotics using the agar diffusion method. J Antimicrob Chem 61:1295–1301. https://doi.org/10.1093/jac/dkn090
Boukaew S, Cheirsilp B, Prasertsan P, Yossan S (2021) Antifungal effect of volatile organic compounds produced by Streptomyces salmonis PSRDC-09 against anthracnose pathogen Colletotrichum gloeosporioides PSU-03 in postharvest chili fruit. J Appl Microbiol 131:1452–1463. https://doi.org/10.1111/jam.15037
Cannon PF, Damm U, Johnston PR, Weir BS (2012) Colletotrichum – current status and future directions. Stud Mycol 73:181–213. https://doi.org/10.3114/sim0014
Chater KF, Biró S, Lee KJ, Palmer T (2010) The complex extracellular biology of Streptomyces. FEMS Microbiol Rev 34:171–198. https://doi.org/10.1111/j.1574-6976.2009.00206.x
Cheng J, Yang SH, Palaniyandi SA, Jung Sun Han JS (2010) Azalomycin F complex is an antifungal substance produced by Streptomyces malaysiensis MJM1968 isolated from agricultural soil. J Korean Soc Appl Biol Chem 53:545–552. https://doi.org/10.3839/jksabc.2010.084
Choudhary B, Nagpure A, Gupta RK (2015) Biological control of toxigenic citrus and papaya-rotting fungi by Streptomyces violascens MT7 and its extracellular metabolites. J Basic Microbiol 55:1343–1356. https://doi.org/10.1002/jobm.201500323
Chowdhury MNA, Rahim MA (2009) Integrated crop management to control anthracnose (Colletotrichum gloeosporioides) of mango. J Agric Rural Dev 7:115–120. https://doi.org/10.3329/jard.v7i1.4430
Dean R, Van Kan JA, Pretorius ZA, Hammnd-Kosack KE, Di Pietro A, Spanu PD, Rudd JJ, Dickman M, Kahmann R, Ellis J, Foster GD (2012) The top 10 fungal pathogens in molecular plant pathology. Mol Plant Pathol 13:414–430. https://doi.org/10.1111/j.1364-3703.2011.00783.x
Di Francesco A, Martini C, Mari M (2016) Biological control of postharvest diseases by microbial antagonists: how many mechanisms of action? Eur J Plant Pathol 145:711–717. https://doi.org/10.1007/s10658-016-0867-0
Edirisinghe M, Ali A, Maqbool M, Alderson PG (2014) Chitosan controls postharvest anthracnose in bell pepper by activating defense-related enzymes. J Food Sci Technol 51(12):4078–4083. https://doi.org/10.1007/s13197-012-0907-5
Evangelista-Martínez Z (2014a) Isolation and characterization of soil Streptomyces species as a potential biological control agent against fungal plant pathogens. World J Microbiol Biotechnol 30:1639–1647. https://doi.org/10.1007/s11274-013-1568-x
Evangelista-Martínez Z (2014b) Preliminary study on some actinomycetes and evaluation of their potential antagonism against fungal pathogens. British Microbiol Res J 4:272–281. https://pdfs.semanticscholar.org/d6db/4c7729acb0481ff236e75629e8f1cf2f47b2.pdf. Accessed 22 Nov 2019
Franco-Correa M, Quintana A, Duque C, Suarez C, Rodríguez MX, Barea JM (2010) Evaluation of actinomycete strains for key traits related with plant growth promotion and mycorrhiza helping activities. Appl Soil Ecol 45:209–217. https://doi.org/10.1016/j.apsoil.2010.04.007
Giblin FR, Tan YP, Mitchell R, Coates LM, Irwin JAG, Shivas RG (2018) Colletotrichum species associated with pre-and post-harvest diseases of avocado and mango in eastern Australia. Australas Plant Pathol 47:269–276. https://doi.org/10.1007/s13313-018-0553-0
Gonçalves DDC, Ribeiro WR, Gonçalves DC, Menini L, Costa H (2021) Recent advances and future perspective of essential oils in control Colletotrichum spp.: A sustainable alternative in postharvest treatment of fruits. Food Res Inter 150(Pt A):110758. https://doi.org/10.1016/j.foodres.2021
González I, Ayuso-Sacido A, Anderson A, Genilloud O (2005) Actinomycetes isolated from lichens: evaluation of their diversity and detection of biosynthetic gene sequences. FEMS Microbiol Ecol 54:401–415. https://doi.org/10.1016/j.femsec.2005.05.004
Hoefler BC, Stubbendieck RM, Josyula NK, Moisan SM (2017) A link between linearmycin biosynthesis and extracellular vesicle genesis connects specialized metabolism and bacterial membrane physiology. Cell Chem Biol 24:1238–1249. https://doi.org/10.1016/j.chembiol.2017.08.008
Ikeda H, Ishikawa J, Hanamoto A, Shinose M (2003) Complete genome sequence and comparative analysis of the industrial microorganism Streptomyces avermitilis. Nat Biotechnol 21:526–531. https://doi.org/10.1038/nbt820
Kamle M, Kumar P (2016) Colletotrichum gloeosporioides: pathogen of anthracnose disease in mango (Mangifera indica L.). In: Kumar P., Gupta V., Tiwari A., Kamle M. (eds) Current Trends in Plant Disease Diagnostics and Management Practices. Fungal Biology. Springer, Cham. https://doi.org/10.1007/978-3-319-27312-9_9
Khaliq G, Mohamed MTM, Ding P, Ghazali HM, Ali A (2016) Storage behaviour and quality responses of mango (Mangifera indica L.) fruit treated with chitosan and gum arabic coatings during cold storage conditions. Int Food Res J 23:141–148. http://ifrj.upm.edu.my/23%20(06)%202016%20supplementary/(21)%20IFRJ-16323%20Khaliq.pdf. Accessed 7 Jan 2022
Khaliq G, Ullah M, Memon SA, Ali A, Rashid M (2021) Exogenous nitric oxide reduces postharvest anthracnose disease and maintains quality of custard apple (Annona squamosa L.) fruit during ripening. J Food Meas Charact 15:707–716. https://doi.org/10.1007/s11694-020-00658-z
Korsten L (2006) Advances in control of postharvest diseases in tropical fresh produce. Intl J Postharvest Technol Innov 1:48–61. https://doi.org/10.1504/IJPTI.2006.009181
Kumar A, Reddy N, Reddy K, Devi M (2007) Evaluation of fungicidal resistance among Colletotrichum gloeosporioides isolates causing mango anthracnose in agri-export zone of Andhra Pradesh, India. Plant Pathol Bull 16:157–160. http://140.112.183.156/pdf/16-3/p157-160.pdf. Accessed 14 Nov 2019
Kumar S, Stecher G, Tamura K (2016) MEGA7: Molecular Evolutionary Genetics Analysis version 7.0 for bigger datasets. Mol Biol Evol 33:1870–1874. https://doi.org/10.1093/molbev/msw054
Lawson T, Lycett GW, Ali A, Chin CF (2019) Characterization of Southeast Asia mangoes (Mangifera indica L) according to their physicochemical attributes. Sci Hortic 243:189–196. https://doi.org/10.1016/j.scienta.2018.08.014
Li Q, Bu J, Shu J, Shu J, Yu Z, Tang L, Huang S, Guo T, Mo J, Luo S, Solangi GS, Hsiang T (2019) Colletotrichum species associated with mango in southern China. Sci Rep 9:18891. https://doi.org/10.1038/s41598-019-54809-4
Li Q, Chen X, Jiang Y, Jiang C (2016) Morphological identification of actinobacteria. In: Dhanasekaran D, Jiang Y (eds). Actinobacteria -Basics and biotechnological applications. India: InTech. https://doi.org/10.5772/61461
Limon T, Birke A, Monribot-Villanueva JL, Guerrero-Analco JA, Altúzar-Molina A, Carrión G, Aluja M (2021) Chitosan coatings reduce fruit fly (Anastrepha obliqua) infestation and development of the fungus Colletotrichum gloeosporioides in Manila mangoes. J Sci Food Agric 101:2756–2766. https://doi.org/10.1002/jsfa.10903
Luo S, Wan B, Feng S, Shao Y (2015) Biocontrol of postharvest anthracnose of mango fruit with Debaryomyces nepalensis and effects on storage quality and postharvest physiology. J Food Sci 80:2555–2563. https://doi.org/10.1111/1750-3841.13087
Nautiyal CS (1999) An efficient microbiological growth medium for screening phosphate solubilizing microorganisms. FEMS Microbiol Lett 170:265–270. https://doi.org/10.1111/j.1574-6968.1999.tb13383.x
Nelson SC (2008) Mango anthracnose (Colletotrichum gloeosporioides). In: College of Tropical Agriculture and Human Resources (CTAHR) University of Hawaii at Mänoa, Editor. Plant Disease. University of Hawaii. PD-48. Honolulu. https://www.ctahr.hawaii.edu/oc/freepubs/pdf/pd-48.pdf. Accessed 19 Dec 2019
Nesher I, Barhoom S, Sharon A (2008) Cell cycle and cell death are not necessary for appressorium formation and plant infection in the fungal plant pathogen Colletotrichum gloeosporioides. BMC Biol 6:9. https://doi.org/10.1186/1741-7007-6-9
Osborn AM, Moore ER, Timmis KN (2000) An evaluation of terminal-restriction fragment length polymorphism (T-RFLP) analysis for the study of microbial community structure and dynamics. Environ Microbiol 2:39–50. https://doi.org/10.1046/j.1462-2920.2000.00081.x
Osorio JA, Martínez EP, Hío JC (2012) Screening of microbial culture filtrates, plant extracts and fungicides for control of mango anthracnose. Agron Colom 30:222–229. http://www.scielo.org.co/pdf/agc/v30n2/v30n2a09.pdf. Accessed 6 Dec 2019
Palaniyandi SA, Yang SH, Zhang L, Suh JW (2013) Effects of actinobacteria on plant disease suppression and growth promotion. Appl Microbiol Biotechnol 97:9621–9636. https://doi.org/10.1007/s00253-013-5206-1
Rey T, Dumas B (2017) Plenty is no plague: Streptomyces symbiosis with crops. Trends Plant Sci 22:30–37. https://doi.org/10.1016/j.tplants.2016.10.008
Rojo-Báez I, Álvarez-Rodríguez B, García-Estrada RS, León-Félix J (2017) Current status of Colletotrichum spp. in Mexico: Taxonomy, characterization, pathogenesis and control. Mexican J Phytopathol 35:549–570. https://doi.org/10.18781/R.MEX.FIT.1703-9
Sadeghian M, Bonjar GHS, Sirchi GRS (2016) Post harvest biological control of apple bitter rot by soil-borne actinomycetes and molecular identification of the active antagonist. Postharvest Biol Technol 112:46–54. https://doi.org/10.1016/j.postharvbio.2015.09.035
Sawicka B (2019) Post-harvest Losses of Agricultural Produce. In: Leal Filho W, Azul A, Brandli L, Özuyar P, Wall T (eds) Zero Hunger. Encyclopedia of the UN Sustainable Development Goals. Springer, Cham. https://doi.org/10.1007/978-3-319-69626-3
Saxena A, Raghuwanshi R, Gupta VK, Singh HB, Mahavidyalaya M (2016) Chilli anthracnose: the epidemiology and management. Front Microbiol 4:1–53. https://doi.org/10.3389/fmicb.2016.01527
Saxena S (2014) Microbial metabolites for development of ecofriendly agrochemicals. Allelopathy J 33:1–24. http://www.esc.org.cn/module/download/downfile.jsp?classid=-1&filename=1901081713522873922.pdf. Accessed 13 Jan 2020
Schrempf H, Koebsch I, Walter S, Engelhardt H (2011) Extracellular Streptomyces vesicles: amphorae for survival and defence. Microbial Biotechnol 4:286–299. https://doi.org/10.1111/j.1751-7915.2011.00251.x
Schrempf H, Merling P (2015) Extracellular Streptomyces lividans vesicles: composition, biogenesis and antimicrobial activity. Microbial Biotechnol 8:644–658. https://doi.org/10.1111/1751-7915.12274
Schwartz D, Berger S, Heinzelmann E, Muschko K (2004) Biosynthetic gene cluster of the herbicide phosphinothricin tripeptide from Streptomyces viridochromogenes Tü494. Appl Environ Microbiol 70:7093–7102. https://doi.org/10.1128/AEM.70.12.7093-7102.2004
Shimizu M, Yazawa S, Ushijima Y (2009) A promising strain of endophytic Streptomyces sp. for biological control of cucumber anthracnose. J Gen Plant Pathol 75:27–36. https://doi.org/10.1007/s10327-008-0138-9
Shirling EB, Gottlieb D (1966) Methods for characterization of Streptomyces species. Int J Syst Bacteriol 16:313–340. https://doi.org/10.1099/00207713-16-3-313
Siddiqui Y, Ali A (2014) Colletotrichum gloeosporioides (Anthracnose). In: Bautista-Baños S (ed) Postharvest Decay. Academic Press. https://doi.org/10.1016/B978-0-12-411552-1.00011-9
Singh SB, Zink DL, Dorso K, Motyl M (2009) Isolation, structure, and antibacterial activities of lucensimycins D-G, discovered from Streptomyces lucensis MA7349 using an antisense strategy. J Nat Prod 72:345–352. https://doi.org/10.1021/np8005106
Torres-Calzada C, Tapia-Tussell R, Higuera-Ciapara I, Martin-Mex R, Nexticapan-Garcez A, Perez-Brito D (2015) Sensitivity of Colletotrichum truncatum to four fungicides and characterization of thiabendazole-resistant isolates. Plant Dis 99(11):1590–1595. https://doi.org/10.1094/PDIS-11-14-1183-RE
Tovar-Pedraza JM, Mora-Aguilera JA, Nava-Diaz C, Lima NB, Michereff SJ, Sandoval-Islas JS, Cámara MPS, Téliz-Ortiz D, Leyva-Mir SG (2019) Distribution and pathogenicity of Colletotrichum species associated with mango anthracnose in Mexico. Plant Dis 104:137–146. https://doi.org/10.1094/PDIS-01-19-0178-RE
Trejo-Estrada SR, Rivas SI, Crawford DL (1998) In vitro and in vivo antagonism of Streptomyces violaceusniger YCED9 against fungal pathogens of turfgrass. World J Microbiol Biotech 14:865–872. https://doi.org/10.1023/A:1008877224089
Wu CJ, Chen HK, Ni HF (2020) Identification and characterization of Colletotrichum species associated with mango anthracnose in Taiwan. Eur J Plant Pathol 157:1–15. https://doi.org/10.1007/s10658-020-01964-4
Wu L, Chen G, Feng G (2017) Complete genome sequence of Streptomyces griseochromogenes ATCC 14511T, a producer of nucleoside compounds and diverse secondary metabolites. J Biotechnol 249:16–19. https://doi.org/10.1016/j.jbiotec.2017.03.017
Yuan WM, Crawford DL (1995) Characterization of Streptomyces lydicus WYEC108 as a potential biocontrol agent against fungal root and seed rots. Appl Environ Microbiol 61:3119–3125. https://aem.asm.org/content/aem/61/8/3119.full.pdf. Accessed 25 Oct 2019
Zhang Y, Li S, Jiang D, Kong L (2013) Antifungal activities of metabolites produced by a termite-associated Streptomyces canus BYB02. J Agric Food Chem 61:1521–1524. https://doi.org/10.1021/jf305210u
Funding
This study was partially supported by funds granted by FOMIX Conacyt-Aguascalientes No. AGS-2011-C02-181930, PIT-CIATEJ No. 1006200001 and PN-2016–2900.
Author information
Authors and Affiliations
Corresponding author
Ethics declarations
Ethical approval
This article does not contain any studies with human participants or animals performed by any of the authors.
Conflict of interest
All authors declare that they have no conflict of interest.
Additional information
Publisher's Note
Springer Nature remains neutral with regard to jurisdictional claims in published maps and institutional affiliations.
Supplementary information
Below is the link to the electronic supplementary material.
Rights and permissions
About this article
Cite this article
Evangelista-Martínez, Z., Ek-Cen, A., Torres-Calzada, C. et al. Potential of Streptomyces sp. strain AGS-58 in controlling anthracnose-causing Colletotrichum siamense from post-harvest mango fruits. J Plant Pathol 104, 553–563 (2022). https://doi.org/10.1007/s42161-022-01104-3
Received:
Accepted:
Published:
Issue Date:
DOI: https://doi.org/10.1007/s42161-022-01104-3